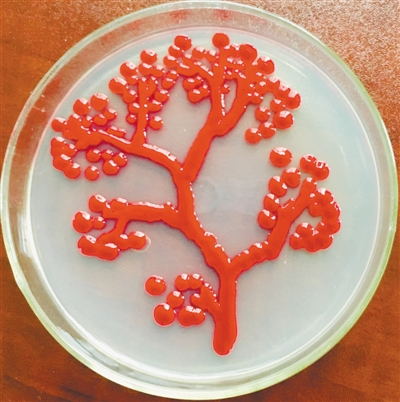

提到微生物,你第一时间会想起什么?是致人死亡的疾病,还是有益于肠道健康的菌群?在科学家的眼中,微生物有了另一个用途:“画画”的好材料。
色彩绚丽的嫦娥奔月图、季节变换春夏秋冬四季景色……近日,沈阳药科大学生命科学与制药学院的学生们在老师的指导下,以培养皿做画布,微生物做“颜料”,完成了一幅幅精美的艺术作品——其实,这些绚丽的色彩,是微生物自己“长”出来的。
别小看了这小小的微生物画作,它链接起了科学研究链条的两端,既能培养学生对学习本专业的兴趣,也可以在高大上的论文中扮演重要角色。
不同菌种产生不同颜色
直径9厘米的培养皿、按照流程消毒后的实验器材、稀释后的土壤标本……准备好这些材料,可以开始绘制一幅“画作”了。近日,沈阳药科大学生命科学与生物制药学院上演了一幕别开生面的画展:利用微生物作画。
在培养皿里,各种不同的菌株摇曳多姿,或是散落满地的洁白冰花,或呈现一片春花盛开的景色,或者是模仿秋天落叶的一片金黄;除了景色,九色鹿、蒙娜丽莎甚至校园的大门……红色的红球菌,黄色的黄杆菌,橙色的橙色单胞菌,白色的芽孢杆菌,有绿色绒毛的青霉菌,还有能产生各种颜色色素的链霉菌等等微生物,将它们的艺术之美演绎得淋漓尽致。
该校负责此次比赛的穆老师介绍,微生物作画的原理其实就是菌种的培养,从自然环境中找到合适的菌种,根据它们自身不同的颜色,利用无菌操作等方式,让菌种长成一幅漂亮的画。
菌株想要长成一幅画,最大的难点是对“颜料”的提纯。一旦混入了其他细菌或者纯化程度不足,就无法取得预料之中的色彩。想要解决这个问题,就必须按照科学研究的规律和实验规范来进行操作。
“实验室中各个步骤的无菌操作是对同学们的第一大要求。”沈阳药科大学生命科学与制药学院副院长、教授张怡轩介绍说,而参加本次画展的每一位同学,都严格遵守了实验要求:首先,实验中使用的培养皿、竹签等都要先经121℃高温高压湿热灭菌30分钟才能使用;其次,操作前要先将工作台空间中的微生物紫外照射30分钟杀灭,操作过程中也要避免微生物的侵入;最后,工作台上一直要吹动过滤过的无菌风,同时燃着酒精灯形成无菌区域。在此三重无菌保障下,一幅幅美丽的作品才能诞生。
从指导学生学习操作规范到挑选菌种、纯化培养,再到一个个带有颜色的斑点慢慢成长,最终长成一幅色彩斑斓的作品,前后共花费了一个多月的时间。“看着菌株一点点长大,最后按照我们的想法长成一幅画,这种感觉特别奇妙,充满了乐趣,”参赛选手、沈阳药科大学生物工程专业本科生王爽说。
小细菌背后的大学问
细菌分为很多种类,如何选择有用的细菌,并对其进行处理,是整个微生物研究环节的第一步。以这次画展为例,绘画使用的“原材料”也就是细菌,主要来源于原始森林植物根部的土壤和部分中药材,许多菌种都是学生们暑假期间到大别山考察时带回来的。
从大别山采集回来后,他们采用梯度稀释涂布法,将药用植物灵芝、天麻、西洋参等中药材的根际土壤进行处理;接下来通过三区划线法等方式进行纯化扩大,将每一种“颜料”单独挑出、层层分离、纯化、扩大,如此再三,才能得到各种单一颜色的“颜料”。
那么,这些作品的图案是怎样形成的呢?
细菌虽然个体微小,但生长总是比较规矩,菌种接种在哪里它就生长在哪里,给它一道线条它就长成一条道路,给它一片区域它就长成一座山峰;而真菌个体相对较大,它的孢子能够到处飘扬而不可控,落在这里形成一朵,落在那里形成一片。于是,菌种一般被用来勾勒出线条,而真菌孢子则形成锦簇的花团,或者波涛汹涌的云海。
学会收集、分离和处理菌株
对于亲手制作微生物作品的同学们来说,这次比赛还有着更深层次的意义。“我们的初衷希望让学生们学到更多知识,对科学研究产生兴趣,更可以让他们了解到科学研究究竟是如何进行的。”张怡轩说。
张怡轩介绍,收集、分离和处理菌株,本身就是该学院的一项重要工作。因为学院建设有沈阳药科大学药用物质资源库——微生物资源中心,主持了国家自然基金项目、科技部“自然科技资源平台—药用微生物资源中心”建设子课题,所保存的各类微生物菌种已达1万余株,共鉴定为280余属,1240余种。菌种来源于土壤、水体、洞穴、药用植物内生、肠道及各种极端环境,用于科学研究。
张怡轩告诉科技日报记者,微生物资源中心成立以来,已经取得了多项重大成果,维生素C生产菌就是其中之一。
我国维生素C发酵工业年产在16万吨以上,占世界总产能的90%,是国内医药领域的支柱性产业之一,更是辽宁省制药业辉煌时代的象征之一。依托于微生物资源库,张怡轩率领团队对维生素生产流程中的关键步骤进行优化,升级了传统方法中微生物菌种,完成了混菌体系的全基因组测序、蛋白质组学分析及在发酵不同阶段下的转录组分析,明确了混菌体系中一系列生理活性物质在菌株互作、代谢物交互过程中的作用及机制。新的工艺节约企业年运行成本1000万元以上。
通过进一步研究,张怡轩团队还利用微生物资源中心从土壤中分离出不需要大菌伴生即可独立生长产酸的小菌SPU_B003,并通过菌株体内碳代谢流改造及系列关键功能基因的敲除、补充及增强等手段,对候选菌株发酵能力进行增强,有望提升二步发酵效率,降低生产成本,从而创造可观的效益。
“对菌种的筛选,其实就是微生物资源中心这些科研活动的一部分,通过这次画展,学生们既可以学到知识,对微生物学科产生兴趣,同时还能参与到深层次的科学研究中来,让学生们拥有很强的参与感,如果其中有人因此而愿意投身科研事业,更是一举多得。”张怡轩说。